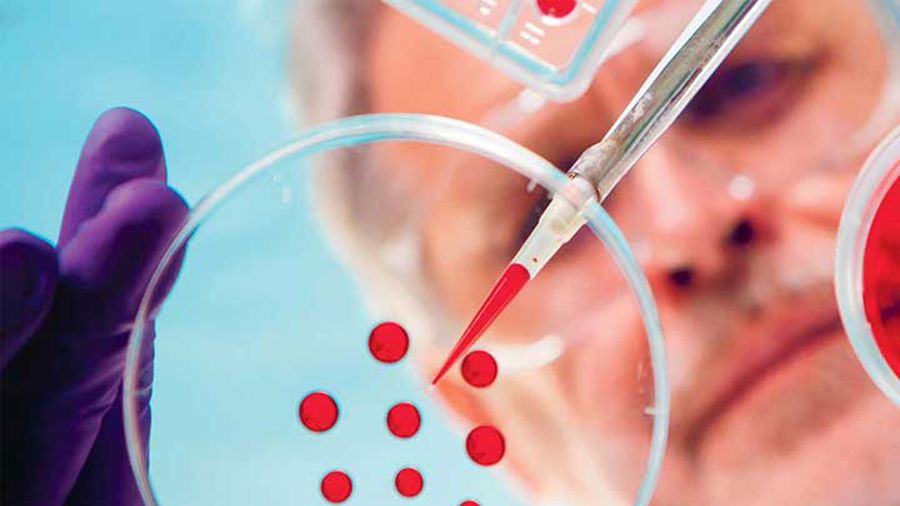

Barncancerrapporten 2019
Årets rapport undersöker bland annat hur den svenska vårdens uppföljning av vuxna barncanceröverlevare ser ut i dag och hur den kan bli bättre.
Till rapportenDin vara har lagts i varukorgen Gå direkt till kassan eller

Årets rapport undersöker bland annat hur den svenska vårdens uppföljning av vuxna barncanceröverlevare ser ut i dag och hur den kan bli bättre.
Till rapporten
Årets rapport undersöker under vilka omständigheter cancerdrabbade barn i Sverige behandlas eller deltar i kliniska studier utomlands.
Till rapporten
2017 års rapport har den nya generationens cancerbehandlingar i fokus.
Till rapporten
Rapporten fokuserar på vikten av infrastruktur – såsom register, biobanker och nätverk.
Till rapporten
Fokus i 2015 års rapport är vårdforskning och det viktiga forskningssamarbetet.
Till rapporten
Temat i Barncancerrapporten 2014 är hjärntumörer och neuroblastom.
Till rapporten
Fokus i årets rapport är leukemi. Det är den vanligaste cancerdiagnosen bland barn och ungdomar.
Till rapporten